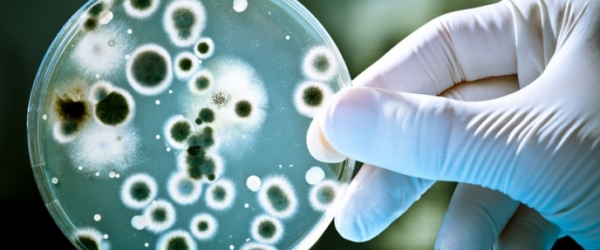

Minciunile profitabile ale stiintei (Partea I): Virusurile patogene
Unde sunt dovezile pentru existenţa virusurilor patogene? (Dr. biol. Stefan Lanka – martie 2002) ~~Material preluat, adaptat si completat de pe site-ul pretios al prietenului qui bono ~~ Izolarea virusurilor Prin izolarea unui virus se înţelege izolarea lui din celule, lichide umorale sau culturi de celule şi eliberarea (curăţarea) lui de orice fel de particule...

Da mai departe